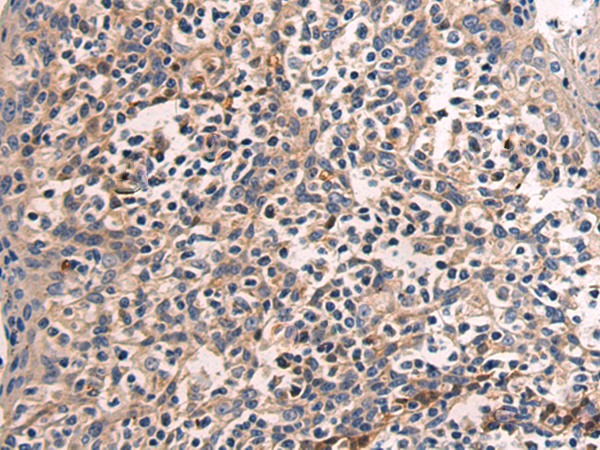
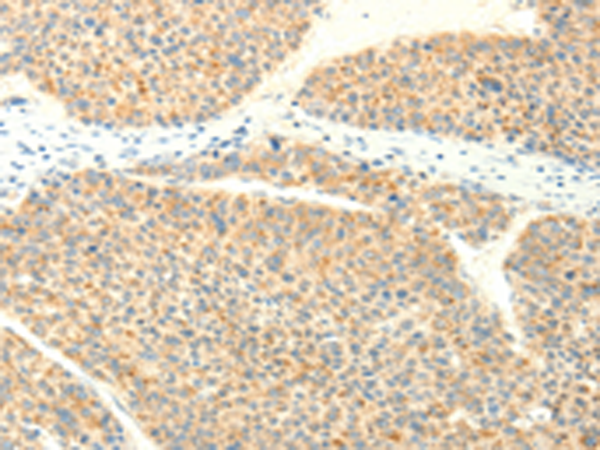

-
分类: 科研抗体货号: P07625别名: ASV; SRC1; c-SRC; p60-Src应用: WB,IHC反应种属: Human, Mouse, Rat
-
分类: 科研抗体货号: P07658别名: TGC; tTG; G(h); hTG2; TG(C)应用: WB,IHC反应种属: Human, Mouse
-
分类: 科研抗体货号: P07644别名: MLK1; MEKK9; PRKE1应用: IHC反应种属: Human, Mouse
-
分类: 科研抗体货号: P07657别名: CSD; CDB1; CDG2; CSD1; CSD2; CSD3; EBMD; LCD1; BIGH3; CDGG1应用: WB,IHC反应种属: Human, Mouse, Rat
-
分类: 科研抗体货号: P07662别名: RIG1; TIG3; HRSL4; HRASLS4; PLAAT-4; RARRES3; PLA1/2-3应用: IHC反应种属: Human
-
分类: 科研抗体货号: P07643别名: LC3; LC3A; ATG8E; MAP1ALC3; MAP1BLC3应用: IHC反应种属: Human, Mouse, Rat
-
分类: 科研抗体货号: P07656别名: EGRA; TIEG; TIEG1; EGR-alpha应用: WB反应种属: Human, Mouse, Rat
-
分类: 科研抗体货号: P07661别名:应用: IHC反应种属: Human, Mouse, Rat
-
分类: 科研抗体货号: P07677别名: ACT1; CIKS; C6orf2; C6orf4; C6orf5; C6orf6; PSORS13应用: WB,IHC反应种属: Human
-
分类: 科研抗体货号: P07655别名: CED; LAP; DPD1; TGFB; TGFbeta应用: IHC反应种属: Human, Mouse, Rat

鄂公网安备42018502007531号
鄂公网安备42018502007531号

